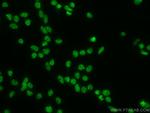
ANP32A Antibody in Immunocytochemistry (ICC/IF)

Search
Proteintech
ANP32A Monoclonal Antibody (2D8C5)
{{$productOrderCtrl.translations['antibody.pdp.commerceCard.promotion.promotions']}}
{{$productOrderCtrl.translations['antibody.pdp.commerceCard.promotion.viewpromo']}}
{{$productOrderCtrl.translations['antibody.pdp.commerceCard.promotion.promocode']}}: {{promo.promoCode}} {{promo.promoTitle}} {{promo.promoDescription}}. {{$productOrderCtrl.translations['antibody.pdp.commerceCard.promotion.learnmore']}}
产品信息
67687-1-IG
种属反应
宿主/亚型
分类
类型
克隆号
抗原
偶联物
形式
浓度
规格
纯化类型
保存液
内含物
保存条件
运输条件
产品详细信息
Aliquoting is unnecessary for -20°C storage.
靶标信息
PHAP I is implicated in a number of cellular processes, including proliferation, differentiation, caspase-dependent and caspase-independent apoptosis, suppression of transformation (tumor suppressor), inhibition of protein phosphatase 2A, regulation of mRNA trafficking and stability in association with ELAVL1, and inhibition of acetyltransferases as part of the INHAT (inhibitor of histone acetyltransferases) complex. Plays a role in E4F1-mediated transcriptional repression.
仅用于科研。不用于诊断过程。未经明确授权不得转售。
篇参考文献 (0)
生物信息学
蛋白别名: Acid nuclear phosphoprotein 32 (leucine rich); acidic (leucine-rich) nuclear phosphoprotein 32 family, member A; Acidic leucine-rich nuclear phosphoprotein 32 family member A; acidic nuclear phosphoprotein 32; acidic nuclear phosphoprotein 32 family, member A; Acidic nuclear phosphoprotein pp32; cerebellar leucine rich acidic nuclear protein; epididymis secretory sperm binding protein; hepatopoietin Cn; I1PP-2A; inhibitor-1 of protein phosphatase-2A; LANP; Leucine-rich acidic nuclear protein; leucine-rich acidic nuclear protein LANP; Mapmodulin; MGC119787; MGC150373; PHAPI; Potent heat-stable protein phosphatase 2A inhibitor I1PP2A; pp32; Putative HLA-DR-associated protein I; putative human HLA class II associated protein I; unnamed protein product; vacidic (leucine-rich) nuclear phosphoprotein 32 family, member A
基因别名: Anp32; ANP32A; C15orf1; HPPCn; I1PP2A; LANP; MAPM; PHAP1; PHAPI; PP32; W91701
UniProt ID: (Human) P39687, (Rat) P49911, (Mouse) O35381
Entrez Gene ID: (Human) 8125, (Rat) 25379, (Mouse) 11737